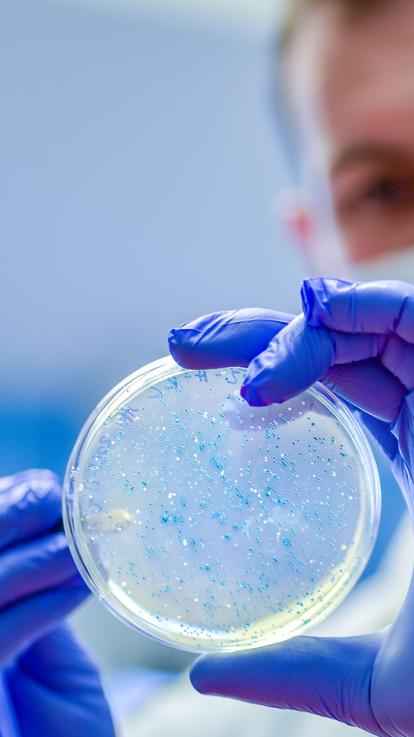
petrischaal

كيف يعمل اللقاح؟
Ook interessant om te weten
هولندا الآن

Laatste update: 03-12-2021

يسبب اللقاح استثارة في جهاز المناعة.
مما يقيك من الإصابة بأمراض معينة.

يحتوي اللقاح على جزء من مسبب المرض، مثل البكتيريا أو الفيروس.
غالباً يكون جزءاً مضعّفاً أو ميتاً.
العثور على المادة الملائمة يحتاج رحلة بحث طويلة.
على الباحثين اتباع خطوات دقيقة.
يبدأون برسم خارطة لمكونات الفيروس أو البكتيريا.
ثم يبحثون عن الجزء الذي يعتقدون أنه هو الذي يخلق الاستجابة المطلوبة في جهاز المناعة.

بواسطة جزء من الفيروس نستطيع تمرين جهاز المناعة.
خوربن بايلمان
عالم فيروسات

بعد العثور على الجزء المسبب للمرض، يصبح بالإمكان إنتاج نسخة منه.
البكتيريا يمكن زرعها في حاضنة خاصة.
الفيروسات لا تعيش إلا داخل الخلايا البشرية أو الحيوانية. في المختبرات يستخدمون لهذا الغرض بيوض الدجاج مثلاً أو خلايا مأخوذة من الحشرات.
يتم زرع نسخ من أجزاء من الفيروس، وهي البروتينات، في خلايا الحشرات. مقطع: المعرفة الآن- NTR
هل أصبح اللقاح جاهزاً؟
كلا. في هذه المرحلة لم يتضح بعد إن كانت المادة تعمل بشكل سليم كلقاح.
لذلك تبدأ مرحلة طويلة من الاختبارات على الحيوانات والبشر. هل هي فعالة وهي هي آمنة؟
أم إنها ليست فعالة وتسبب أضراراً جانبية؟ في هذه الحالة تبدأ رحلة البحث من البداية مجدداً.

كيف يعمل اللقاح؟





